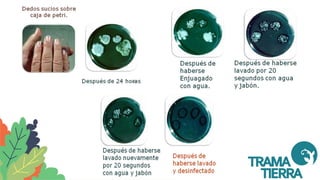

Este documento trata sobre la manipulación segura de alimentos y contiene 3 oraciones o menos:
El documento define qué es un manipulador de alimentos, qué es un alimento, y explica la importancia de seguir buenas prácticas de manipulación de alimentos a lo largo de toda la cadena alimentaria para garantizar la seguridad e inocuidad de los alimentos.